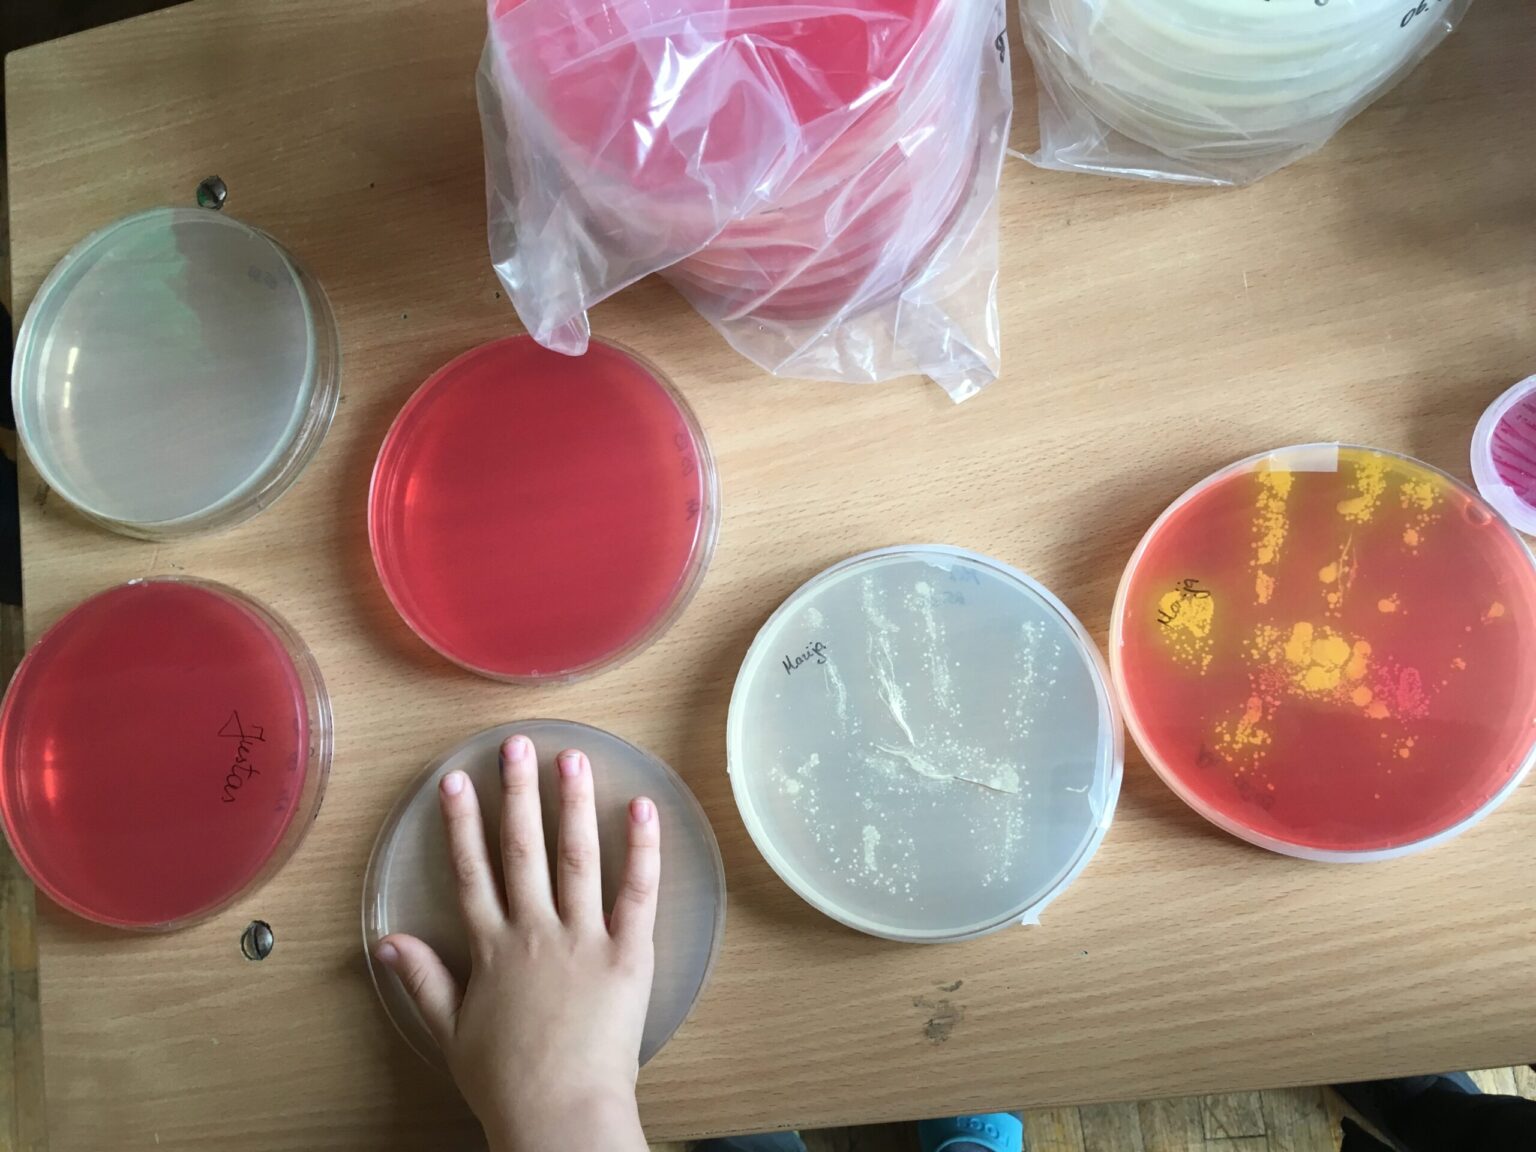
Net 80 proc. infekcinių ligų plinta per nešvarias rankas. Šis faktas atrodo dar baisiau pagalvojus, jog dažnai net nesuprantame, kada būtina rankas plauti.
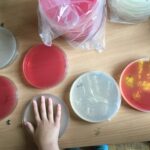
Net 80 proc. infekcinių ligų plinta per nešvarias rankas. Šis faktas atrodo dar baisiau pagalvojus, jog dažnai net nesuprantame, kada būtina rankas plauti.
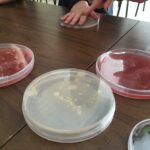

Net 80 proc. infekcinių ligų plinta per nešvarias rankas. Šis faktas atrodo dar baisiau pagalvojus, jog dažnai net nesuprantame, kada būtina rankas plauti. Naujausių tyrimų duomenimis, ant kiekvieno mobilaus telefono paviršiaus yra kelis kartus daugiau bakterijų nei ant durų rankenų ar tualeto sėdynių, tad valgant maistą žaisti su telefonu – tai suteikti mikrobams kelią tiesiai į valgančiojo skrandį.
Siekiant užtikrinti vaikų sveikatą būtina nuo jauno amžiaus mokyti vaikus kaip valgant nepaversti sveiko maisto ligos nešėju. Šiandien tai ypač aktualu, mat bakterijas to nesuprasdami mes nešiojame ant kiekvieno kišeninio prietaiso, o nesusikūrus įpročio prieš maistą plautis rankas šie mikrobai gali sukelti rimtų sveikatos sutrikimų.
Pasaulinės rankų higienos dienos proga šiemet jau ketvirtus metus įmonė „Pontem“ ir Nacionalinis maisto ir veterinarijos rizikos vertinimo institutas (toliau – Institutas) vykdo tradicija tapusį projektą „Švarios rankos – mikrobams patrankos“. Iniciatyvos tikslas – atkreipti moksleivių bei mokyklų bendruomenių dėmesį į asmeninės higienos svarbą sveikatai. Vis labiau rūpinantis sveiku vaikų maistu svarbu nepamiršti, jog net šviežiausi produktai nenuplautose rankose virsta žalingais.
Kėdainių Kupos pradinėje mokykloje antradienį, gegužės 9 d., Instituto specialistai ėmė mėginius nuo vaikų rankų. Patys moksleiviai galėjo įsitikinti, kiek ir kokių bakterijų slepiasi ant jų delnų, bei sužinoti daugiau apie taisyklingo rankų plovimo naudą.
„Asmeninės higienos privalu mokytis nuo vaikystės. Ypač tai svarbu šiandien, kai vaikai žaidžia lauke, važinėja miesto transportu, o namuose, mokykloje naudojasi kompiuteriais bei telefonais. Labai svarbu rankas plauti prieš valgį – tai žinome nuo vaikystės. Tačiau moksleiviai ne visada klauso patarimų plautis rankas ar elementariai pamiršta tai daryti, todėl mūsų tikslas yra parodyti jiems higienos reikšmę netradiciniais būdais. Tikimės, jog taip galėsime išauginti visam gyvenimui liksiančius gerus įpročius“, – tikina įmonės „Pontem“ vykdantysis direktorius Donatas Garbauskas.
Didmenine maisto produktų prekyba užsiimančios bei maitinimo paslaugas ugdymo įstaigoms teikiančios įmonės vadovas teigia, jog dėl kontakto su nenuplautomis rankomis visapusiškai maistingi produktai, šviežiai paruošti patiekalai gali virsti nuodu. Dėl netinkamos ar per retos rankų higienos galima užsikrėsti tokiomis infekcinėmis ligomis kaip rotavirusinisenteritas, norovirusinė infekcija, šigeliozė, virusiniai hepatitai A ir E, išauga rizika užsikrėsi tuberkulioze, gripu, tymais, meningokokine infekcija, difterija bei parazitinėmis ligomis.
Mėginius iš Kupiškio Kupos pradinės mokyklos tyrusio Nacionalinio maisto ir veterinarijos rizikos vertinimo instituto Bakteriologinių tyrimų skyriaus vedėja Česlova Butrimaitė Ambrozevičienė pasakoja, jog svarbu įprasti rankas plauti ne tik grįžus į namus, prieš maisto ruošimą ir valgymą, po kontakto su gyvūnais, pasinaudojus tualetu, bet tai įprasti daryti tiesiog reguliariai.
Anot specialistės, dar svarbiau už rankų plovimo dažnį yra procedūros atlikimo teisingumas: „Higieniškas rankų plovimas užtrunka 30 sekundžių-minutę. Pirmiausiai rankas reikėtų gerai sudrėkinti vandeniu, po to – išmuiluoti, atidžiai nutrinant delnus, išorines plaštakų puses, tarpupirščius, pirštų galiukus. Galiausiai, svarbu vandens čiaupą, ypač jei rankas plaunate viešoje vietoje, užsukti naudojantis vienkartiniu rankšluosčiu, mat liečiant jį plika ranka vėl pasigaunamos bakterijos“.
Pasaulinės rankų higienos dienos proga „Pontem“ rengia akcijas trijų Lietuvos miestų mokyklose. Gegužės 5 dieną akcija vyko Vilniaus mieste, o gegužės 10 dieną Instituto specialistai apsilankys Kėdainiuose.